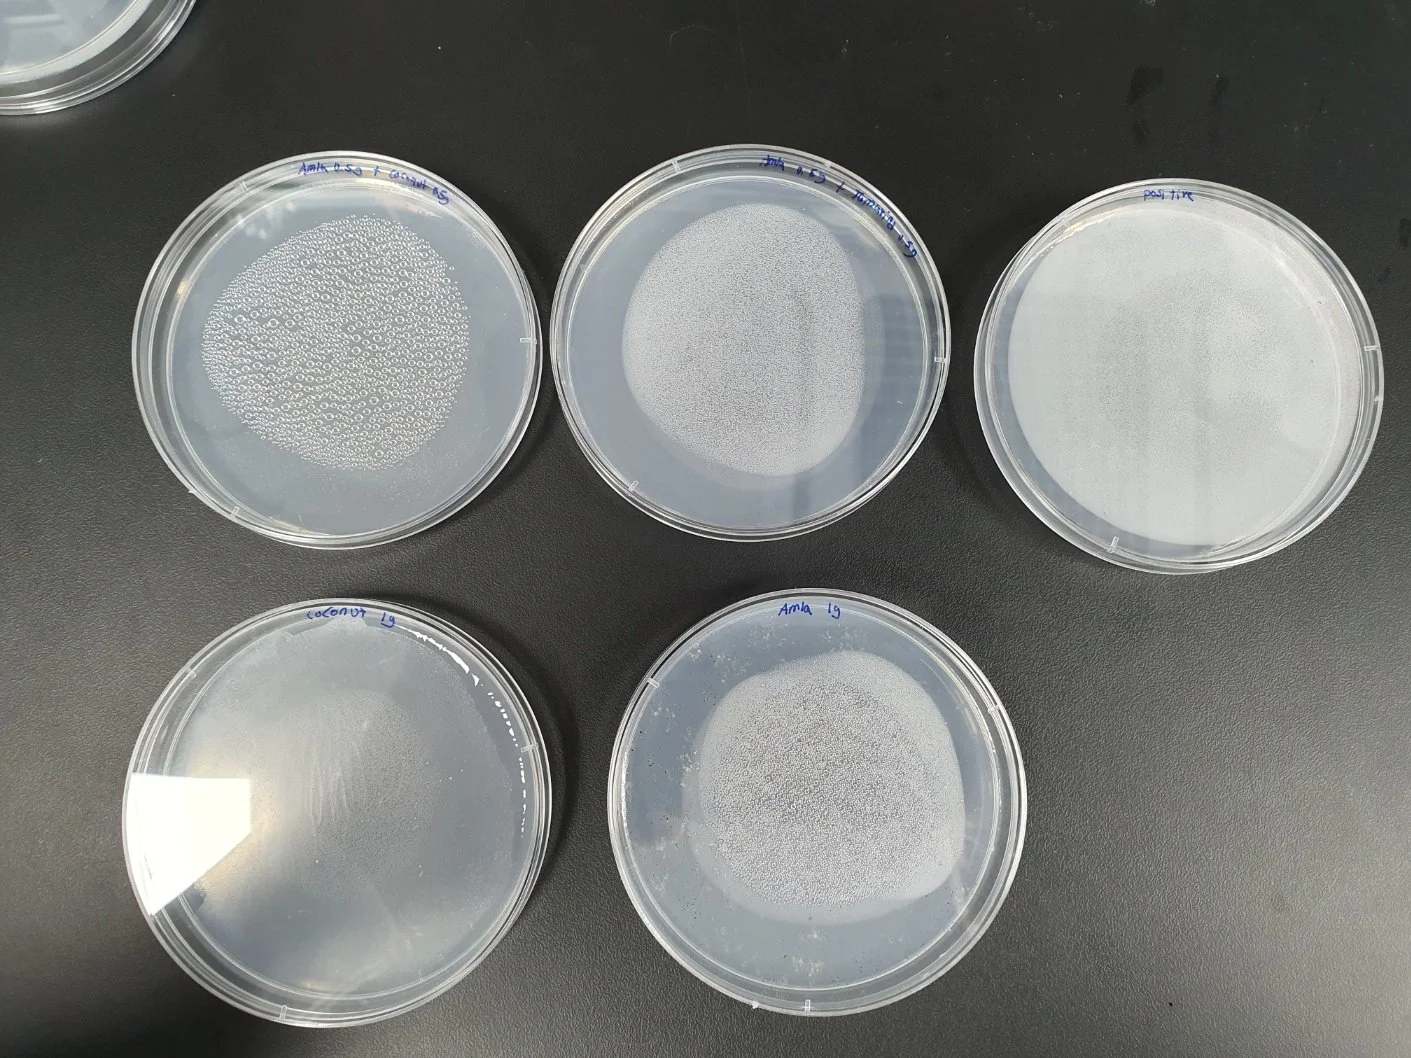

Suwon University
research program
Development of Cost-effective E. coli Bacteria Disinfectant for Water Purification in India
Selected for a competitive research program at Suwon University after proposing a solution to waterborne bacteria in India.
Presented my findings at conferences and published the research in the IYRC Journal.
Independently tested natural materials like coconut husk and tamarind for their disinfectant properties against E. coli and created an eco-friendly water filter that proved highly effective.
2024.06 - 2024.08